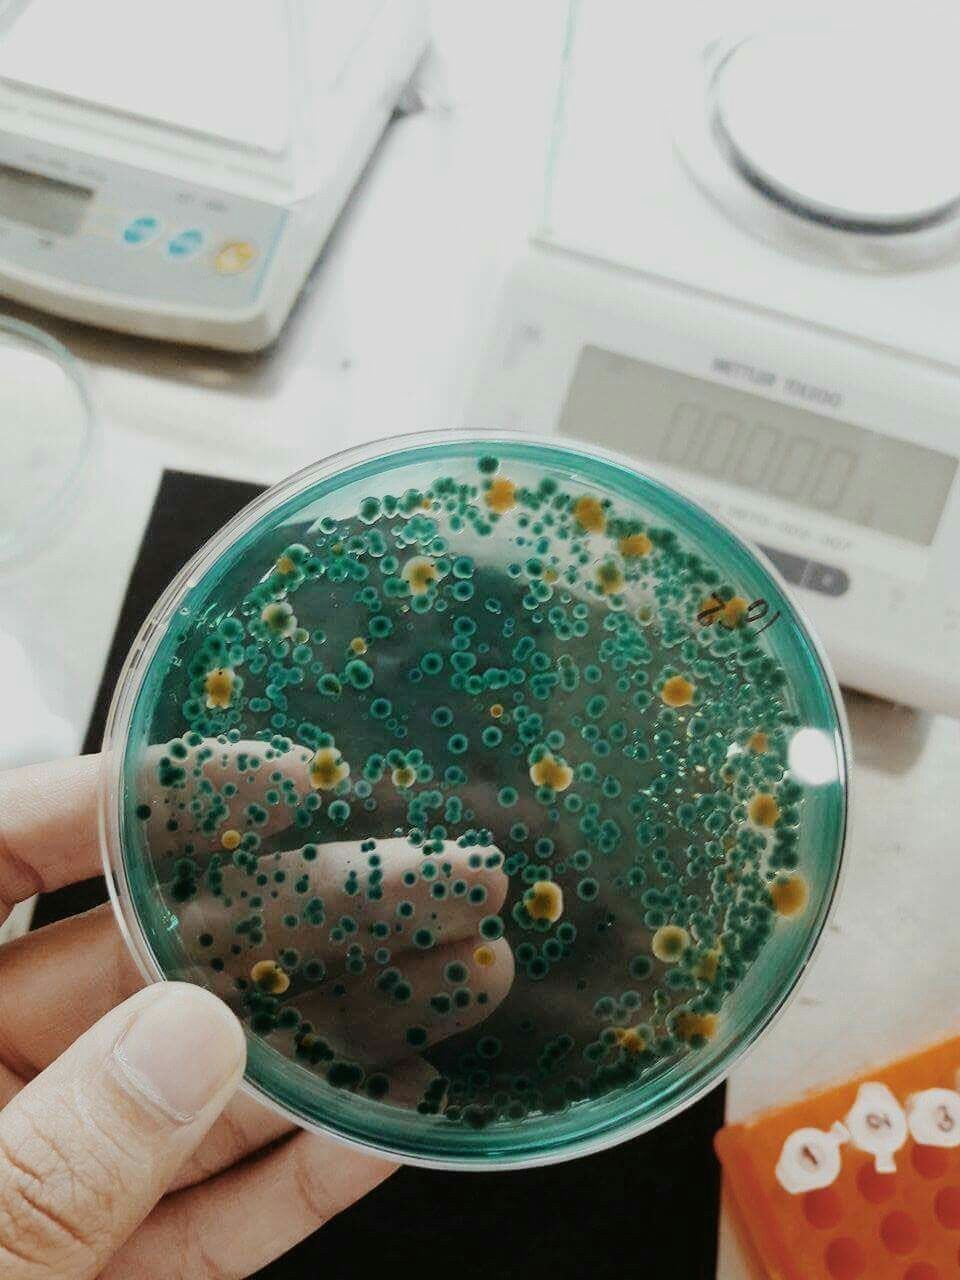

สวัสดีค่า เราชื่อ ทองใบ นามสกุล ไฉไลจริงจริง (นามสมมติ) ตอนนี้เราเป็นนิสิตอยู่ที่ มหาวิทยาลัยศรีนครินทรวิโรฒ ( องครักษ์ ) หรือที่เรียกกันสั้นๆว่า มศว ไม่มีจุด มีแต่ตุ๊ดกับกะเทย (ล้อเล่น อิอิ ) เราเรียนคณะที่มีชื่อโคตรยาววว... นั่นก็คือ คณะเทคโนโลยีและนวัตกรรมผลิตภัณฑ์การเกษตร หรือเรียกย่อๆว่า “เอไอ”ซึ่งมาจาก Agriculture Product Innovation Technology ก่อนอื่นเลยเราต้องขอบอกก่อนว่าคณะของเรานั้นมีอยู่ 3 สาขา นั่นคือ ลองมาเซ สโม และเอกมัย อ้าวววว ไม่ใช่ละ !! เอาใหม่นะ สาขาที่ 1. สาขาวิทยาศาสตร์การอาหารและโภชนาการ (หรือเรียกสั้นๆว่า ฟู้ดไซน์) 2. สาขาเทคโนโลยีวัสดุพอลิเมอร์ ( เรียกสั้นๆว่าพอลิเมอร์ ) และ 3. สาขาเทคโนโลยีชีวภาพและผลิตภัณฑ์การเกษตร (เรียกสั้นๆว่า ไบโอเทค) ก่อนอื่นเราจะมาเล่าประสบการณ์ตั้งแต่ก้าวแรกที่เข้ามาในรั้วมหาวิทยาลัยแห่งนี้ เริ่มแรกเราติดรับตรง ตอนแรกเราก็ไม่รู้หรอกว่า คณะนี้ สาขานี้ เรียนเกี่ยวกับอะไร เราเห็นชื่อมันเท่ห์ดี เราก็เลยลองสอบดู สุดท้ายก็ได้เข้ามาเรียนที่นี่ ตอนแรกเรายังไม่รู้จักใครเลยสักคน แต่มีรุ่นพี่คนนึงได้แอด Facebook เรามา แล้วก็บอกเราว่าเป็นรุ่นพี่ที่คณะและแจ้งกำหนดการกิจกรรมรับน้องกัน ตอนนั้นเราตื่นเต้นมาก เราจะได้เจอเพื่อนใหม่ พอถึงวันรับน้องพี่ๆก็มีกิจกรรมให้เราทำ สนุกมากก และยังได้ทำให้เราได้รู้จักกับเพื่อนใหม่ในคณะอีกหลายคน ละพอใกล้เปิดเทอม ก็มีกิจกรรมอัตลักษณ์ ซึ่งเด็ก ปี 1 ต้องเข้าทุกคน เอ้ออ.. ลืมบอกไปเด็กปี 1 ที่อยู่องครักษ์ สามารถเลือกที่จะพักอยู่ในหอพักในมหาวิทยาลัยหรือไม่ก็ได้ แต่ส่วนใหญ่แล้วจะอยู่หอในกันเกือบทุกคน เพราะสะดวกในการไปเรียน และทำกิจกรรม กิจกรรมอัตรลักษณ์มีกิจกรรมตามฐานแล้วก็มีคอนเสิร์ต จัดขึ้นที่ยิม 1 จะมีการเล่นโค้ดของคณะ เพื่อเป็นการทำความรู้จักกันซึ่งจะมีพี่ๆสอนและเมื่อจบกิจกรรมแล้วคณะของเราก็จะเป็นที่รู้จักและน่าจดจำของคณะอื่นๆ เพราะโค้ดที่น่ารักๆของเรานั่นเอง ในช่วงเปิดเทอม ปี 1 เทอม 1 เรียนพื้นฐานทั่วไป พวกวิชา ฟิสิกส์ เคมี ชีวะ ปี 1 เทอม 2 หลักๆจะเคมี 2 และจุลชีววิทยา ซึ่งเราจะได้ส่องเชื้อแบคทีเรียต่างๆด้วยนะ ปี 2 เทอม 1 มีวิชาปราบเซียนเข้ามา คือ เคมีอินทรีย์ แคลคูลัส ปี 2 เทอม 1 มีวิชาปราบเซียนเข้ามา คือ เคมีอินทรีย์ และแคลคูลัส ถามว่าเราชอบมั๊ยย ตอบเลยว่าไม่ได้ A 555 บางวิชามีแลปให้ทำกรุบกริบ แก้เซ็ง

.. =∆= ปี 2 เทอม 2 มีวิชาปราบเทพอย่างเราเพิ่มมาอีก 2 วิชา คือ ฟิเคม และ แอลนอล บอกเลยเรากวาดเอมาทุกตัว (กวาดมันทิ้งไป อิอิ) แต่ถ้าตั้งใจเรียนก็ไม่ยากหรอก อาจารย์ใจดี ผ่านอยู่แล้วทุกคน ซึ่งปี 1 และ ปี 2 ทั้ง 3 สาขาจะเรียนเหมือนๆกัน ก็จะเริ่มเรียนต่างกันตอนปี 3 ปี 4 ในช่วงปี 3 เทอม 1 เราจะได้เจอวิชาที่พีคมาก ยิ่งกว่าวิชาปราบเซียน คือ วิชา Bioprocess ซึ่งวิชานี้ผ่านไปได้ก็สบายละ ปี 3 เทอม 2 เนี่ยกำลังเรียนอยู่เลย กำลังฝ่าฟันอุปสรรค จะได้เรียนวิชาภาคแบบจริงๆจังๆ เราจะได้ขึ้นรูปพลาสติกด้วยนะ สนุกเลยทีเดียว ส่วนสาขาฟู้ดไซน์จะเรียนการทำพวกอาหารอบแห้ง เช่น กีวี่ แอปเปิ้ล เป็นต้น ซึ่งจะได้ลองใช้เครื่องและลองทำกันจริงๆ นอกจากนี้ก็ได้ทำไวน์ ทำบราวนี และขนมต่างด้วยนะ สุดท้ายสาขาไบโอเทคเป็นหลักสูตรสองภาษาอ่ะ เรียนทั้งไทยและอังกฤษ มีการทำแลปที่แบบว่าอาจารย์ให้โจทย์ปัญหามาแล้วเราต้องหาให้ได้อ่ะ เช่น อาจารย์ต้องหาเชื้อนี้....... ที่ผลิตกรด......เราจะหาเชื้อมาได้ยังไง และมีการหาผู้ชนะในการทำแลปนี้ด้วย กลุ่มไหนชนะจะได้คะแนนเพิ่มไปเลยแบบไม่หาร .....งานนี้ใครดีใครได้บอกเลย ไม่มีคำว่า ปราณี 55555


แล้วช่วงนี้ทั้ง 3 สาขาก็เริ่มมีการทำพรีโปรเจค หัวใจจะวายก็ตอนลุ้นว่าจะได้อาจารย์คนไหนเป็นที่ปรึกษาโปรเจค ส่วนปี 4 จะเป็นยังไงต้องติดตามกันต่อไป อ่าาา.. เรื่องเรียนผ่านไป มาสู่เรื่องการใช้ชีวิตประจำวันกันดีกว่า
จริงๆการใช้ชีวิตอยู่องครักษ์ก็ไม่ได้แย่อย่างที่ใครๆหลายคนคิด เราใช้ชีวิตอยู่ด้วยกันแบบพี่น้อง อยู่กันแบบครอบครัว 55555 ตื่นเช้ามาก็อาบน้ำแต่งตัวไปเรียนตอนเที่ยงก็มีที่กินข้าวที่ดีอิ่มทั้งท้อง อิ่มทั้งตา อิ่มทั้งใจที่โรงอาหารหอหรือที่ชาวเอไอเรียกโรงเขียว เพราะโรงอาหารทาสีเขียวและโรงอาหารวิศวะหรือ วศ อิอิ แล้วพอเรียนเสร็จตอนเย็นก็ไปออกกำลังกายมีหลายกีฬา เช่น ฟิตเนส ว่ายน้ำ ปันจักรยาน วิ่งและอื่นๆ มีร้านกาแฟ ร้านอาหาร ให้นั่งชิลล์ๆได้


ส่วนเจ้าของกระทู้ชอบไปปั่นจักรยานที่วงเวียนเพราะชอบไปส่อง... มันดีต่อใจจริงๆ. 5555 อยู่องครักษ์อาหารตาอาหารใจดีอะ (คนสวยๆหล่อเยอะแยะไปหมด) คณะที่ใหญ่ๆก็เรียนกันที่นี่ พละ วิศวะ เภสัช ฯลฯ ที่สำคัญอากาศดีนะต้นไม้เยอะดีใครว่าองครักษ์ร้อนป่าวเเลยไม่ร้อนเลยแค่ผิวไหม้ ผิวไหม้เฉยๆ 555555 -0-


นี่ก็เป็นส่วนหนึ่งของการใช้ชีวิตที่องครักษ์ ถ้าอยากเรียนรู้ อยากใช้ชีวิต สนุกๆ ก็มาเรียนที่เอไอ กันเยอะๆนะคะ ยินดีต้อนรับน้องๆทุกคนน้าาา…

สำหรับวันนี้ ต้องขอตัวลาไปก่อน แล้วพบกันใหม่ กับ ทองใบ ไฉไลจริงจริง สวัสดีค่าาา


ทองใบพาทัวร์ “เอไอ” มศว
สวัสดีค่า เราชื่อ ทองใบ นามสกุล ไฉไลจริงจริง (นามสมมติ) ตอนนี้เราเป็นนิสิตอยู่ที่ มหาวิทยาลัยศรีนครินทรวิโรฒ ( องครักษ์ ) หรือที่เรียกกันสั้นๆว่า มศว ไม่มีจุด มีแต่ตุ๊ดกับกะเทย (ล้อเล่น อิอิ ) เราเรียนคณะที่มีชื่อโคตรยาววว... นั่นก็คือ คณะเทคโนโลยีและนวัตกรรมผลิตภัณฑ์การเกษตร หรือเรียกย่อๆว่า “เอไอ”ซึ่งมาจาก Agriculture Product Innovation Technology ก่อนอื่นเลยเราต้องขอบอกก่อนว่าคณะของเรานั้นมีอยู่ 3 สาขา นั่นคือ ลองมาเซ สโม และเอกมัย อ้าวววว ไม่ใช่ละ !! เอาใหม่นะ สาขาที่ 1. สาขาวิทยาศาสตร์การอาหารและโภชนาการ (หรือเรียกสั้นๆว่า ฟู้ดไซน์) 2. สาขาเทคโนโลยีวัสดุพอลิเมอร์ ( เรียกสั้นๆว่าพอลิเมอร์ ) และ 3. สาขาเทคโนโลยีชีวภาพและผลิตภัณฑ์การเกษตร (เรียกสั้นๆว่า ไบโอเทค) ก่อนอื่นเราจะมาเล่าประสบการณ์ตั้งแต่ก้าวแรกที่เข้ามาในรั้วมหาวิทยาลัยแห่งนี้ เริ่มแรกเราติดรับตรง ตอนแรกเราก็ไม่รู้หรอกว่า คณะนี้ สาขานี้ เรียนเกี่ยวกับอะไร เราเห็นชื่อมันเท่ห์ดี เราก็เลยลองสอบดู สุดท้ายก็ได้เข้ามาเรียนที่นี่ ตอนแรกเรายังไม่รู้จักใครเลยสักคน แต่มีรุ่นพี่คนนึงได้แอด Facebook เรามา แล้วก็บอกเราว่าเป็นรุ่นพี่ที่คณะและแจ้งกำหนดการกิจกรรมรับน้องกัน ตอนนั้นเราตื่นเต้นมาก เราจะได้เจอเพื่อนใหม่ พอถึงวันรับน้องพี่ๆก็มีกิจกรรมให้เราทำ สนุกมากก และยังได้ทำให้เราได้รู้จักกับเพื่อนใหม่ในคณะอีกหลายคน ละพอใกล้เปิดเทอม ก็มีกิจกรรมอัตลักษณ์ ซึ่งเด็ก ปี 1 ต้องเข้าทุกคน เอ้ออ.. ลืมบอกไปเด็กปี 1 ที่อยู่องครักษ์ สามารถเลือกที่จะพักอยู่ในหอพักในมหาวิทยาลัยหรือไม่ก็ได้ แต่ส่วนใหญ่แล้วจะอยู่หอในกันเกือบทุกคน เพราะสะดวกในการไปเรียน และทำกิจกรรม กิจกรรมอัตรลักษณ์มีกิจกรรมตามฐานแล้วก็มีคอนเสิร์ต จัดขึ้นที่ยิม 1 จะมีการเล่นโค้ดของคณะ เพื่อเป็นการทำความรู้จักกันซึ่งจะมีพี่ๆสอนและเมื่อจบกิจกรรมแล้วคณะของเราก็จะเป็นที่รู้จักและน่าจดจำของคณะอื่นๆ เพราะโค้ดที่น่ารักๆของเรานั่นเอง ในช่วงเปิดเทอม ปี 1 เทอม 1 เรียนพื้นฐานทั่วไป พวกวิชา ฟิสิกส์ เคมี ชีวะ ปี 1 เทอม 2 หลักๆจะเคมี 2 และจุลชีววิทยา ซึ่งเราจะได้ส่องเชื้อแบคทีเรียต่างๆด้วยนะ ปี 2 เทอม 1 มีวิชาปราบเซียนเข้ามา คือ เคมีอินทรีย์ แคลคูลัส ปี 2 เทอม 1 มีวิชาปราบเซียนเข้ามา คือ เคมีอินทรีย์ และแคลคูลัส ถามว่าเราชอบมั๊ยย ตอบเลยว่าไม่ได้ A 555 บางวิชามีแลปให้ทำกรุบกริบ แก้เซ็ง
.. =∆= ปี 2 เทอม 2 มีวิชาปราบเทพอย่างเราเพิ่มมาอีก 2 วิชา คือ ฟิเคม และ แอลนอล บอกเลยเรากวาดเอมาทุกตัว (กวาดมันทิ้งไป อิอิ) แต่ถ้าตั้งใจเรียนก็ไม่ยากหรอก อาจารย์ใจดี ผ่านอยู่แล้วทุกคน ซึ่งปี 1 และ ปี 2 ทั้ง 3 สาขาจะเรียนเหมือนๆกัน ก็จะเริ่มเรียนต่างกันตอนปี 3 ปี 4 ในช่วงปี 3 เทอม 1 เราจะได้เจอวิชาที่พีคมาก ยิ่งกว่าวิชาปราบเซียน คือ วิชา Bioprocess ซึ่งวิชานี้ผ่านไปได้ก็สบายละ ปี 3 เทอม 2 เนี่ยกำลังเรียนอยู่เลย กำลังฝ่าฟันอุปสรรค จะได้เรียนวิชาภาคแบบจริงๆจังๆ เราจะได้ขึ้นรูปพลาสติกด้วยนะ สนุกเลยทีเดียว ส่วนสาขาฟู้ดไซน์จะเรียนการทำพวกอาหารอบแห้ง เช่น กีวี่ แอปเปิ้ล เป็นต้น ซึ่งจะได้ลองใช้เครื่องและลองทำกันจริงๆ นอกจากนี้ก็ได้ทำไวน์ ทำบราวนี และขนมต่างด้วยนะ สุดท้ายสาขาไบโอเทคเป็นหลักสูตรสองภาษาอ่ะ เรียนทั้งไทยและอังกฤษ มีการทำแลปที่แบบว่าอาจารย์ให้โจทย์ปัญหามาแล้วเราต้องหาให้ได้อ่ะ เช่น อาจารย์ต้องหาเชื้อนี้....... ที่ผลิตกรด......เราจะหาเชื้อมาได้ยังไง และมีการหาผู้ชนะในการทำแลปนี้ด้วย กลุ่มไหนชนะจะได้คะแนนเพิ่มไปเลยแบบไม่หาร .....งานนี้ใครดีใครได้บอกเลย ไม่มีคำว่า ปราณี 55555
แล้วช่วงนี้ทั้ง 3 สาขาก็เริ่มมีการทำพรีโปรเจค หัวใจจะวายก็ตอนลุ้นว่าจะได้อาจารย์คนไหนเป็นที่ปรึกษาโปรเจค ส่วนปี 4 จะเป็นยังไงต้องติดตามกันต่อไป อ่าาา.. เรื่องเรียนผ่านไป มาสู่เรื่องการใช้ชีวิตประจำวันกันดีกว่า
จริงๆการใช้ชีวิตอยู่องครักษ์ก็ไม่ได้แย่อย่างที่ใครๆหลายคนคิด เราใช้ชีวิตอยู่ด้วยกันแบบพี่น้อง อยู่กันแบบครอบครัว 55555 ตื่นเช้ามาก็อาบน้ำแต่งตัวไปเรียนตอนเที่ยงก็มีที่กินข้าวที่ดีอิ่มทั้งท้อง อิ่มทั้งตา อิ่มทั้งใจที่โรงอาหารหอหรือที่ชาวเอไอเรียกโรงเขียว เพราะโรงอาหารทาสีเขียวและโรงอาหารวิศวะหรือ วศ อิอิ แล้วพอเรียนเสร็จตอนเย็นก็ไปออกกำลังกายมีหลายกีฬา เช่น ฟิตเนส ว่ายน้ำ ปันจักรยาน วิ่งและอื่นๆ มีร้านกาแฟ ร้านอาหาร ให้นั่งชิลล์ๆได้
ส่วนเจ้าของกระทู้ชอบไปปั่นจักรยานที่วงเวียนเพราะชอบไปส่อง... มันดีต่อใจจริงๆ. 5555 อยู่องครักษ์อาหารตาอาหารใจดีอะ (คนสวยๆหล่อเยอะแยะไปหมด) คณะที่ใหญ่ๆก็เรียนกันที่นี่ พละ วิศวะ เภสัช ฯลฯ ที่สำคัญอากาศดีนะต้นไม้เยอะดีใครว่าองครักษ์ร้อนป่าวเเลยไม่ร้อนเลยแค่ผิวไหม้ ผิวไหม้เฉยๆ 555555 -0-
นี่ก็เป็นส่วนหนึ่งของการใช้ชีวิตที่องครักษ์ ถ้าอยากเรียนรู้ อยากใช้ชีวิต สนุกๆ ก็มาเรียนที่เอไอ กันเยอะๆนะคะ ยินดีต้อนรับน้องๆทุกคนน้าาา…
สำหรับวันนี้ ต้องขอตัวลาไปก่อน แล้วพบกันใหม่ กับ ทองใบ ไฉไลจริงจริง สวัสดีค่าาา